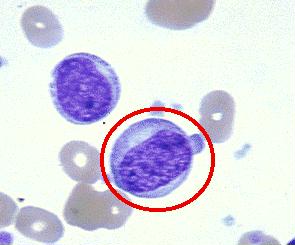
SEZARY綜合徵

流行病學
 漿細胞病理圖
漿細胞病理圖病因:
MF/SS的確切病因尚不明確。一些回顧性調查研究提示環境和職業因素可能與起病相關。曾有報導從事棉花加工業,電車和公共汽車運輸以及建築業的人群中MF或SS的發病危險性增加。另一些研究認為化學物質和殺蟲劑的慢性暴露和刺激與發病相關。但最近一些大規模的病例對照研究結果卻未能發現上述因素與MF或SS的相關性。一些學者在MF/SS病人的外周血或皮膚病灶中檢測到成人T細胞白血病/淋巴瘤病毒(HTLV-1),因此認為HTIV-1感染可能與MF/SS的發生相關。另有研究表明MF/SS的起病可能與組織相容性抗原有關,如Aw31 Aw32、B8、Bw38和DR5等。MF/SS可有1和6號染色體的缺失和易位,但不清楚這些染色體的異常在MF/SS發生、發展中的作用。
發病機制
漿細胞
漿細胞臨床表現
 T淋巴細胞
T淋巴細胞1.MF 病程可以很長,皮損表現多樣,根據疾病發展過程和皮損形態,大致可分為3期,但各期的不同皮損可同時交叉存在。
(1)蕈樣前期:又稱斑片期或濕疹樣期。此期可持續數月、數年,甚至20~30年以上 常見的皮損為非特異性、輕微魚鱗樣皮損,可此起彼伏 易被誤診為濕疹、神經性皮炎、銀屑病、玫瑰糠疹和魚鱗病。此期少數病人皮損可自發消退,不再進展為病理上能診斷的MF 從首次出現皮損到確診MF的肘間長達5年或更長。
(2)浸潤期:又稱斑塊期。由斑片期的皮損發展而來,也可作為MF的首發症狀。表現為不規則浸潤性斑塊,暗紅色 表面光滑或高低不平,浸潤處毛髮常脫落,亦可累及口腔黏膜。皮損常伴明顯的瘙癢。浸潤期皮膚增厚,可出現典型的“獅子樣臉”。此期可於數月後轉入腫瘤期。
(3)腫瘤期:斑塊性皮損可進一步發展為腫瘤,呈潰瘍型或外生蕈傘樣。大多數斑片和斑塊期病人經治療後可不發展為腫瘤期。極少數病人起病一開始就可表現為腫瘤性皮損。
(4)其他:MF的另一種皮損是廣泛性紅皮病,發生率約為10% 可伴或不伴斑塊、腫瘤性皮損。皮膚可萎縮或呈苔蘚樣,常有劇癢,對冷刺激耐受差,常伴淋巴結腫大。
2.SS 紅皮病如伴外周血受侵(循環中異常細胞占淋巴細胞比例>5%) 即稱為Sezary綜合徵,一般認為是MF的特殊類型,臨床表現為剝脫性、浸潤性紅皮病和廣泛淋巴結腫大,手、腳掌皮膚過度角化和增厚,常出現龜裂,指和趾甲營養不良和脫髮常見。皮膚奇癢,是其特徵之一。由於抓撓常導致表皮脫落、滲出和結痂。
併發症:
1.潰瘍性皮損易並發感染和繼發敗血症, 是MF最常見的急性死亡原因。
2.約8%的MF病程中轉化為大細胞淋巴瘤, 從診斷MF到出現轉化的中位時間21.5個月。轉化後病情加速,預後差。15%~20%的MF病程中出現皮膚外臟器侵犯,包括淋巴結和內臟器官。皮膚外臟器侵犯在局限性斑塊和斑片期極少出現,而廣泛性斑塊期發生率8%左右,但腫瘤期和全身性紅皮病時發生率高達30%~42%。皮損早期淺表淋巴結腫大常為皮膚病反應性,既而才出現腫瘤侵犯,常首先累及皮損引流區域範圍內的淺表淋巴結,深部如縱隔和腹主動脈旁淋巴結受侵一般較晚。內臟器官侵犯常出現於淋巴結受侵之後,最常累及肺、脾、肝、中樞神經系統和胃腸道,早期局限性皮損時很少出現骨髓侵犯,但當外周血中有Sezary細胞時,骨髓受侵發生率明顯增加 屍檢資料表明疾病晚期腫瘤可侵犯任何器官。
診斷
 角朊細胞
角朊細胞鑑別診斷:
需與下列疾病鑑別:
1.皮炎濕疹類皮膚病 皮損中常見表皮細胞間的水腫,伴散在分布或聚集的淋巴樣細胞,有時與MF斑片中的向表皮性浸潤細胞和Pautrier微膿腫相似,但這類皮損中常見變性、崩解的角朊細胞,角朊細胞的殘留部分呈星狀彼此相連,而MF往往無明顯細胞間水腫,Pautrier微膿腫內一般無積液,這兩點可供鑑別,但需結合臨床。
2.苔蘚樣皮炎類皮膚病 常見者如扁平苔蘚、藥物反應和神經性皮炎,組織學上真皮淺層淋巴細胞帶狀浸潤並可呈向表皮性,其形態與早期MF細胞相似。因此,見到上述苔蘚樣組織反應時,應注意與MF斑片期的鑑別。
3.銀屑病樣皮炎類皮膚病 常見者如銀屑病、毛髮紅糠疹和玫瑰糠疹等。不典型病例的組織學,可與MF斑片期相似,需結合臨床隨訪區別。
4.光化性網狀細胞增生病 臨床和組織學上有時與MF難以鑑別,須結合病史、光試驗或光斑片貼試驗。
5.淋巴瘤樣丘疹 組織學上B型淋巴瘤樣丘疹也可有胞核深染、不規則多形的不典型細胞,常須結合臨床病史與MF區分,並應注意SEZARY綜合徵少數可轉變為MF。
6.大細胞性淋巴瘤 MF腫瘤期瘤細胞常與皮膚大細胞性淋巴瘤相似,但兩者病史往往不一樣,後者的腫瘤細胞可對CD30呈陽性反應。
實驗室檢查:
1.外周血 早期血紅蛋白正常,晚期可有輕度貧血。有些病例白細胞增加,嗜酸性粒細胞和單核細胞增加,淋巴細胞減少,這在廣泛性斑塊和腫瘤期患者中尤為常見 提示預後差。約20%病人外周血中可找到異常淋巴細胞,占有核細胞數的6%~35% 大多在20%以下。
2.皮損組織 淋巴結找到Sezary細胞。
3.血沉 80%的患者可有不同程度的血沉增快。
4.免疫功能檢測 細胞免疫反應呈陰性或低於正常。螢光檢查示血管壁中有IgG、IgA、IgM和IgD沉積。
其它輔助檢查:
1.骨髓象 局限性皮損期骨髓很少受侵,偶見漿細胞增加。但有SS病人骨髓受侵率明顯增加。
2.根據臨床表現 症狀、體徵選擇X線、CT B超、及生化等檢查。
治療
 表1 SEZARY綜合徵
表1 SEZARY綜合徵1.治療手段
(1)局部化學藥物塗抹:氮芥局部使用時可以製成軟膏或水溶液,水溶液濃度100~200mg/L。全身皮膚塗抹,1次/d。數周后,塗抹範圍可局限於皮損部位,也可一開始即塗抹皮損局部,同時嚴密監視其他部位有無新病灶出現。
(2)電子束照射(electron beam therapy,EBT):包括局部和全身皮膚電子束照射。全身皮膚EBT常規劑量30~36Gy/10周,劑量達18~20Gy時可休息1周,以緩解照射所致的廣泛性皮膚紅斑。
(3)光療法:包括紫外光B照射(ultraviolet B,UVB)和補骨脂素+紫外光A照射(psoralen+ultraviolet A PUVA),是治療MF的重要手段。紫外光A為長波 對MF皮損的穿透能力和深度優於紫外光B。
(4)生物治療:維A酸治療MF/SS主要用於難治性和晚期病變,經口服給藥,常用的包括異維A酸(13-順式維甲酸)、阿維A酯(依曲替酯)和異維A酸(保膚靈)。維A酸單藥的療效與化療、干擾素單藥相近,總有效率58%,CR率19%,中位緩解期3~13個月。
(5)全身化療:MF或SS對化療敏感,大多數化療藥物包括烷化劑、抗代謝類、抗生素類、長春鹼類,拓撲異構酶-Ⅱ抑制劑和皮質類固醇激素均有效。單藥有效率62%左右,CR率33%,中位緩解時間2~22個月。
聯合化療的療效略優於單藥化療,有效率81% CR率38%,中位緩解時間5~41個月。常用的化療方案見表1。
2.各期的治療策略
(1)ⅠA期(局限斑片或斑塊期,T1):局部治療為主,包括局部化學藥物塗抹(多用氮芥)、UVB、PUVA和局部電子束照射 不主張採用全身化療,全身聯合化療療效並不優於單一手段的局部治療。
(2)ⅠBⅡA期(廣泛性斑片或斑塊期,T2):治療方法與T1相似 以局部治療為主:氮芥局抹,光療法(主要為PUVA)或全身皮膚電子束照射。由於UVB穿透力弱,因此只適合於斑片樣皮損。EBT的皮膚穿透能力強於氮芥局抹和UVB或PUVA,因此厚斑塊型皮損應首選全身皮膚EBT。近期病情進展迅速或對氮芥局抹或光療失敗的病人也應選擇全身皮膚EBT,EBT結束後應予氮芥局抹鞏固治療至少6個月。EBT對T2期病變的CR率為80%~90%,氮芥局部治療的CR率為50%~70%。雖然EBT的近期CR率高於氮芥局部治療,但兩者的遠期生存無差別。PUVA的CR率50%~80%。一種治療手段失敗後採用其他方法仍可有效。
(3)ⅡB期(腫瘤期,T3):首選全身皮膚EBT,CR率44%~74%。如皮膚腫瘤數目少,可採用局部氮芥塗抹或PUVA聯合局部皮膚EBT,由於復發率高,EBT後應配合其他方法鞏固治療。Stanford大學的經驗是EBT結束後常規立即予氮芥軟膏局部治療,對全身EBT治療失敗的病人可採用干擾素+PUVA,有效率約80%。對難治性病變應聯合多種全身治療手段(包括全身化療)。
(4)Ⅲ期(紅皮病,T4):如無外周血受侵,首選低劑量PUVA治療,非常緩慢和小心地逐漸增加劑量,以避免光毒性反應。PUVA可單用或與干擾素聯合。PUVA單用治療T4期MF的CR率為33%~70%。大多數病人在PUVA的維持治療階段會復發。一些作者認為聯合治療的有效率和緩解期均優於PUVA或干擾素單一治療,PUVA聯合干擾素的CR和PR率分別為62%和25%。
(5)Ⅳ期(皮膚外病變):首選全身化療聯合其他局部或生物療法,甲氨蝶呤、依託泊苷(足葉乙甙)、博來黴素、硫酸長春鹼(長春花鹼)和嘌呤類似物是治療MF和SS最有效的單藥。化療對病情只能起到姑息控制的作用,大多數病人的中位緩解期<1年。常用的方案包括CHOP(多柔比星(阿黴素)、環磷醯胺、長春新鹼和潑尼松)或CVP(環磷醯胺 長春新鹼和潑尼松),其他方案包括CAVE(環磷醯胺、多柔比星(阿黴素)、長春新鹼和依託泊苷(足葉乙甙))或CVP+甲氨蝶呤(MTX)。化療常與干擾素、維A酸聯合。Foss等報導干擾素和氟達拉濱聯合治療Ⅳ期MF的有效率46%,中位緩解期6.5個月。
3.治療的新進展 臨床試驗中一些新藥對MF或SS有效 如氯達拉賓(fludara),是嘌呤類抗代謝藥,可導致外周血T細胞明顯減少,對MF 慢性淋巴細胞性白血病和低度惡性淋巴瘤有效。另一藥物2-dexyocoformycin 對MF、一些類型的非霍奇金淋巴瘤和毛細胞白血病也有效,治療MF的有效率50%左右,其作用機制是抑制腺苷酸脫氨酶,阻礙DNA的合成,而T細胞中的腺苷酸脫氨酶活性很高。除新藥外 新的生物療法是的研究方向之一,IL-2-毒素的融合蛋白治療MF有一定的療效,有的藥物已進入臨床試驗,總有效率30%,CR率10%。其機制為大多數MF或SS腫瘤細胞表面低表達IL-2受體CD25,少數則高表達。因此與IL-2融合的毒素蛋白能選擇性靶向作用於MF或SS細胞。
預後
 淋巴細胞結構圖
淋巴細胞結構圖Stanford大學曾分析464例MF或SS,中位生存期>10年。T1、T2 T3和T4的10年生存率分別為80%、50%、20% 30%。T1、T2、T3和T4病變的中位生存時間分別為超過33年、10.7、3.3和3.7年。Lamberg等報導Ⅰ、ⅡA、ⅡB、Ⅲ和Ⅳ期的5年生存率分別為80%~90%、60%~70%、30%、40%~50%和25%~35%。LN-1和LN-2的病人5年生存率為80%,LN-3和LN-4期5年生存率分別為30%和15%。有皮膚外臟器侵犯的病人中位生存期1~2.5年。
1.局限性斑片或斑塊期(T1,ⅠA期) 預後良好,大多可獲得長期生存。只有9%的病人病情最終進展。絕大多數病人均死於MF外原因。
2.廣泛性斑片或斑塊期(T2,ⅠB、ⅡA期,無皮膚外臟器受侵) 中位生存期>11年,此期24%的病人會病情進展 20%的病人死於MF相關的原因。ⅡA期的生存率與ⅠB期無差別。
3.ⅡB和廣泛性紅皮病(T4 Ⅲ期) 大多數病人最終死於MF。多因素分析表明T4病人的預後與年齡(>65 與<65歲,中位生存期為6.5 與 2.7年)、淋巴結受侵(受侵與否,中位生存期為4.6 與 1.1年) 外周血受侵(B0 與B1 中位生存期6.8 與 2.6年)相關。
MF轉化為大細胞性淋巴瘤後中位生存期2個月,應予強烈的局部或全身治療。
MF或SS最常見的疾病相關死亡原因為感染,其次為心肺意外和第2個原發腫瘤。常見的第2個原發腫瘤包括非霍奇金淋巴瘤、霍奇金淋巴瘤和結腸癌。
